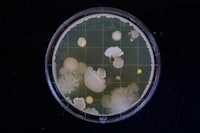
Evaluasi Program melalui E\u002Dlearning Image

Conference paper
Penerapan Model Pembelajaran Group Investigation (Gi) dengan Menggunakan Media Flash Card untuk Meningkatkan Aktivitas Belajar dan Kemampuan Kognitif Siswa
Penelitian ini bertujuan untuk membuktikan: (1) model pembelajaran GI dengan menggunakan media flashcard mampu meningkatkan aktivitas belajar siswa. (2) model pembelajaran GI dengan menggunakan media flashcard mampu meningkatkan kemampuan kognitif siswa..Penelitian ini merupakan penelitian tindakan kelas (classroom action research) dengan model Kurt Lewin dan model kolaboratif yang dilaksanakan dalam dua siklus. Siklus diawali tahap persiapan kemudian dilanjutkan tahap pelaksanaan siklus yang terdiri dari perencanaan tindakan, pelaksanaan tindakan, observasi dan evaluasi, serta refleksi. Subyek penelitian adalah siswa kelas VII E SMP Negeri 16 Surakarta tahun pelajaran 2012/2013 sebanyak 27 siswa dengan penelitian pada materi pemuaian. Data diperoleh melalui pengamatan, wawancara, tes kemampuan kognitif, dan kajian dokumen. Teknik analisis data yang digunakan adalah kuantitatif dan kualitatif.Berdasarkan hasil penelitian, dapat disimpulkan bahwa (1) penerapan model pembelajaran GI dengan menggunakan media flashcard dapat meningkatkan aktivitas belajar siswa. Dari tiga aspek aktivitas belajar yang menjadi fokus penelitian diperoleh hasil sebagai berikut: (a) Visual Activities dapat mencapai 82 %, (b) Oral Activities dapat mencapai 48 %, (c) Writing Activities dapat mencapai 68 %. (2) model pembelajaran GI dengan menggunakan media flashcard dapat meningkatkan kemampuan kognitif siswa. Hal ini dapat terlihat dari meningkatnya persentase ketercapaian ketuntasan belajar siswa yaitu 29,62% pada pra siklus, menjadi 48,14% di siklus I, dan 92,59% di siklus II. Hasil ini telah memenuhi batas Kriteria Ketuntasan Minimal (KKM) SMP Negeri16 Surakarta yaitu 75.